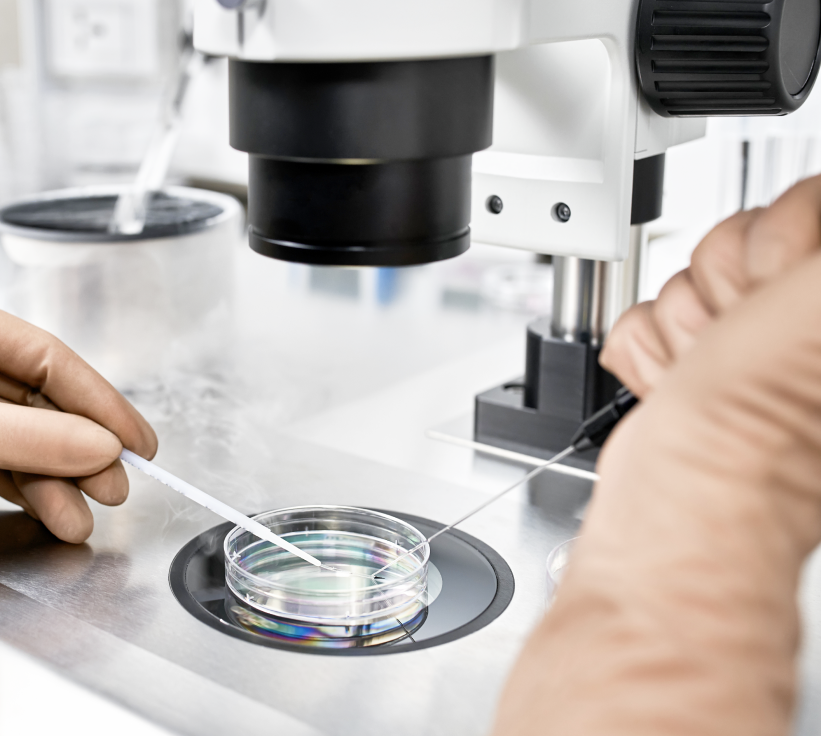
Rectangle 749

Lorem, ipsum dolor sit amet consectetur adipisicing elit. Exercitationem, facere nesciunt doloremque nobis debitis sint?






Regenerative Medicineคือแนวทางการดูแลสุขภาพที่มุ่งเน้นการสนับสนุนกระบวนการฟื้นฟู
ของร่างกาย
โดยใช้เทคโนโลยีทางการแพทย์สมัยใหม่
เช่น สเต็มเซลล์
เพื่อช่วยดูแลและสนับสนุนการทำงานของ
เนื้อเยื่อในระดับเซลล์
Cell Therapy หรือ การรักษาด้วยเซลล์ คือเทคโนโลยีทางการแพทย์สมัยใหม่ที่ใช้ เซลล์ที่มีชีวิต เพื่อช่วยซ่อมแซม
ฟื้นฟู และทดแทนเซลล์ที่เสียหายในร่างกาย แนวคิดนี้เป็นส่วนหนึ่งของศาสตร์ด้าน Regenerative Medicine
ซึ่งเน้นการรักษาที่ต้นเหตุของปัญหาสุขภาพ
ปัจจุบัน Cell Therapy
กำลังได้รับความสนใจอย่างมากในวงการแพทย์ เนื่องจากสามารถช่วยฟื้นฟูระบบต่าง ๆ ของร่างกายได้อย่างมีประสิทธิภาพ
และถูกนำมาใช้ทั้งในด้านการรักษาโรค การฟื้นฟูร่างกาย และการชะลอวัย












การรักษาด้วยเซลล์มีข้อดีหลายประการ
เช่น
เป็นการรักษาที่เน้นฟื้นฟูจากระดับเซลล์
ช่วยซ่อมแซมเนื้อเยื่อที่เสียหายได้โดยตรง
ลดการใช้ยาในระยะยาว
ช่วยฟื้นฟูร่างกายแบบองค์รวม
นอกจากนี้
Cell Therapy ยังถูกพัฒนาอย่างต่อเนื่องในงานวิจัยด้าน Biotechnology
ทำให้มีแนวโน้มว่าจะกลายเป็นหนึ่งในวิธี
การรักษาที่สำคัญของอนาคต



แพทย์ที่ปรึกษา American Board of Anti-Aging

สเต็มเซลล์คือเซลล์ชนิดหนึ่งที่มีความสามารถในการพัฒนาไปเป็นเซลล์ประเภทต่าง ๆ ในร่างกาย เช่น เซลล์ของกระดูกอ่อน กล้ามเนื้อ หรือหลอดเลือด ในทางการแพทย์ สเต็มเซลล์ถูกนำมาใช้เพื่อสนับสนุนกระบวนการฟื้นฟูของร่างกายในระดับเซลล์ ภายใต้การดูแลของแพทย์ผู้เชี่ยวชาญ






 เว็บไซต์นี้ใช้คุกกี้
เว็บไซต์นี้ใช้คุกกี้
เว็บไซต์เราใช้คุกกี้เพื่อเพิ่มประสิทธิภาพและประสบการณ์ที่ดีในการใช้เว็บไซต์ ท่านสามารถศึกษารายละเอียดการใช้คุกกี้ได้ที่ “นโยบายคุกกี้”